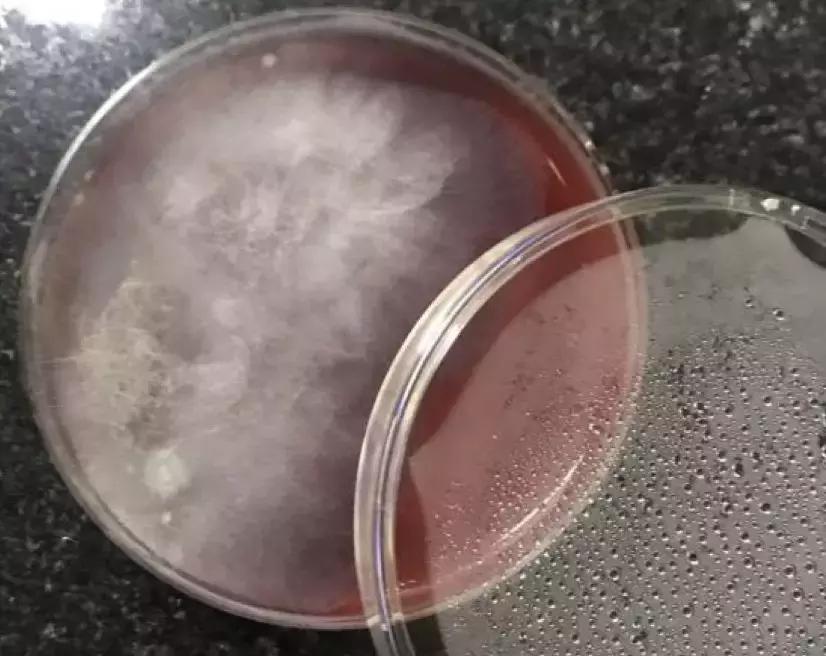
mngs病原检测的优势,mngs真的可靠吗

编前语
肺泡灌洗和痰涂片、mNGS结果均为曲霉菌,痰和肺泡灌洗培养出来的却是根霉菌,哪个环节出了问题?血mNGS结果为猫立克次体,序列总数53152条,而肺泡灌洗却只有5条支原体?二代测序结果为阴道加德纳菌,肺泡灌洗测出70多种细菌,是操作不当还是病人存在严重的卫生问题?
以上实例都是临床使用mNGS时出现的问题,浙大一院呼吸与危重症医学科的周华医生在中青年呼吸学者论坛上进行了分享,那么,mNGS对病原学的诊断与传统方法相比有什么优势?mNGS出现假阴性或假阳性时,我们该怎么办?为何反复强调小心验证的重要性?


在开发出NGS技术之前,即使用遍所有的方法去诊断感染性疾病,还是会面临很多困难,也就是说很多感染性疾病的病人无法及时精准诊断病原体,导致治疗延误或者治疗不当,增加致死率,加重医疗花费。现在应用mNGS技术之后,很多病人还是无法明确病原体,因此我们需要探索新的方法。

目前病原微生物鉴定的检测技术有哪些?

病原学检测方法包括培养和非培养的方法。其中非培养方法包括直接涂片法,多用于细菌、真菌、 分枝杆菌检测;还有抗原/抗体检测,很早以前核酸检测就应用于临床,以前基于PCR技术或者多重PCR技术来做病原体检测,随着二代测序价格下降,二代测序就被用于临床做感染病人的病原学诊断。
mNGS对病原学诊断与传统方法相比,具有什么优势?
mNGS指宏基因组二代测序(Metagenomic Next-generation Sequencing),临床也称之为二代测序、宏基因组测序、高通量测序。

宏基因组测序(Metagenomic Sequencing)对病原学诊断与常规的培养相比具有理论优势。
第一个优势是没有偏移性,比如一个标本中既有曲霉菌又有白色念珠菌,培养时,如果白色念珠菌生长较快,便会影响曲霉菌的生长,假如一口痰中既有白色念珠菌又有奴卡菌,白色念珠菌生长有优势可能影响了奴卡菌的阳性率。所以培养是有偏移性的,但理论上说,宏基因组测序对病原学诊断没有偏移性。
第二个优势是广覆盖,对于常规的感染性疾病的诊断来说,我们根据临床思维,判断高危因素和病原体,选择必要的检测手段,如果评估不全面可能导致漏检。理论上,宏基因组测序可以没有偏移的把标本中所有病原体的核酸都检测出来,所以覆盖面更广。
第三个优势是高效率,可以同时检测多种病原体。
mNGS诊断方法的优势:「一网打尽」

类比一下,传统的病原学检测方法如同钓鱼一样,需要加上诱饵(引物或抗原抗体),一次只钓一种鱼,或者使用多重PCR的方法,放几个鱼钩一起钓,一次性钓几种。而病原宏基因组学方法学就如同撒一张大网去全面覆盖各种病原菌,将可能致病的病原菌一网打尽。
二代测序除了用于病原学诊断,还有哪些用途?

二代测序不仅可以用于病原学检测,也可以在病原培养后做深度的二代测序,甚至全基因组分析。现在主要用于临床的还是临床标本病原学检测,通过检测可以知道标本中含有的病原体。如果测序量能够进一步突破,它除了可以把标本中里所有微生物的核酸测出来外,也可以把人体表达的所有RNA测出来,帮助判断定植或者感染。比如铜绿假单胞菌测出来后,人体有没有针对它产生炎症反应,还可以判断是定植还是感染,但目前还在探索阶段,尚常规未用于临床。
mNGS检测有几步?

目前对于二代测序来说,给它一个临床标本,不经过培养的话,还是只能用于病原学诊断。使用二代测序来做病原学诊断有六个基本步骤,第一个是采集感染部位样本,最后一步是报告解读,中间有四个步骤分别为提取核酸、高通量测序、生物信息分析、检测结果报告,这四步都不由临床医生操作,由实验室技术人员操作完成。其实我们临床医生要做好第一步和最后一步,也要了解中间的四步,在报告解读的时候需要了解其中的技术问题,这样才能读懂报告。

病例一
患者,徐**,男性,59岁,工人。
入院时间:2019-04-01。
主诉:发热、咳嗽15天,胸闷气促7天,ECMO术后6小时。
基础疾病:无。
白细胞计数 5.4×10^9/L,超敏C反应蛋白 147.6mg/L,降钙素原 1.304ng/ml。
目前这个病人还住在我院ICU,是我在外院会诊带回本院。当时由于病人病情严重,不适合转运,所以联系我院ECMO团队,在外院做完ECMO才转入我院。
入院后肺部CT提示双肺弥漫性病变。这个病人是不是重症社区获得性肺炎?


/入院后肺部CT/
入院后进行肺泡灌洗,1小时后微生物室的痰和肺泡灌洗液的涂片报告结果是曲霉菌属,灌洗液荧光涂片显示为典型的曲霉菌丝。所以标本涂片是目前最快的一个微生物学检测方法,比培养、测序都快。

涂片
2天后二代测序回报为两种真菌,一种是白色念珠菌,另一种是烟曲霉菌。

二代测序报告
我们应该相信哪个结果?临床医生肯定相信病人是曲霉菌感染。那么什么高危因素导致这个健康人起病为曲霉菌感染的社区获得性肺炎呢?
又过了1天,患者初诊的浙江省江山市人民医院痰液真菌培养的结果报告,不是曲霉菌,而是根霉菌;我院肺泡灌洗液真菌培养同样是根霉菌。

根霉菌
非常奇怪,这个病人的痰和肺泡灌洗涂片结果、二代测序结果都有曲霉菌,而痰培养出来的结果是根霉菌。
当我看到根霉菌时,马上给测序实验室打电话沟通:为什么培养到大量根霉菌,但二代测序没有测到它?
mNGS在检测真菌和结核菌上存在一定缺陷,敏感性不高,主要问题是真菌(耶氏肺孢子菌除外)或者结核菌用目前的mNGS提取核酸的方法,核酸提取的效率较低,存在假阴性的可能。
测序工作人员把原始数据列出来重新查看,发现有一条根霉菌的序列,但是他们当初认为数据里已经有曲霉菌,判断根霉菌没有临床意义,因此没把根霉菌的结果报给临床。其实我们培养到的是大量的根霉菌。
被扔掉的数据:

被忽略的病史:当我们拿到曲霉菌和根霉菌的结果时,感到很诧异,反复询问病人的病史,了解到病人在发病的1个月之内,在粮站工作、打扫废弃谷仓。
病例二
患者,姚**,男性,17岁。
入院时间:2018-08-30。
主诉:发热11天,胸闷气急3天。
白细胞 5.06*10^9/L、CRP 112.32mg/L。
肺部CT(治疗后)提示双肺弥漫性病变,小叶性肺炎,左下肺斑片状阴影。



由于病人入院时病情严重,担心进行肺泡灌洗对他会有影响,所以进行了血mNGS检测……
结果为猫立克次体,序列总数53152条。

这种感觉就像走在大街上,突然有个美女向你看了过来一样,非常激动!抑制住内心的小冲动,向患者了解了一些问题:
问病史:中学生、无动物密切接触;
改治疗:阿奇霉素改为米诺环素;
结果再分析:所测得立克次体的序列拼接后可覆盖立克次体全基因组60%,肯定不是检测有误。
但是这和我们以前理解的社区获得性肺炎病原学以及猫立克次体感染不同,我们甚至说如果诊断成立,这个病例可以发表很好的文章。理论上,血液里这么多序列数应该不是污染,但是我们得去验证它。
首先找疾控中心测抗体,结果为阴性;一周后再测抗体,还是阴性;与疾控中心方法沟通,抗体范围扩大到不常见的立克次体再测,依旧为阴性;还在疾控中心做了血和肺泡灌洗液培养,一个月后的结果还是阴性。
验证的结果有点失望……就像遇到的美女只是看了你一眼,转身和别人走了。
后来我们在病人情况好转后做肺泡灌洗,结果没有猫立克次体,只有5条支原体。

然后我们给病人做PCR检测,提示支原体DNA阳性,所以这个病人是支原体肺炎。
那么猫立克次体从何而来?到现在也没有答案,估计是污染的。因此对待新事物一定要谨慎,尤其是与临床实践不吻合时一定要充分验证。
病例三
患者,女性,29岁。
入院时间:2019-02-20。
主诉:反复咳嗽咳痰、胸闷气喘1年,加重1月。
白细胞 Wbc 10.1*10^9/L,CRP 13.7。
痰培养:铜绿假单胞菌。
哮喘病史(规范吸入ICS+LABA)。
我们想了解病人有没有导致哮喘控制不佳的高危因素,通过仔细询问病史了解到病人的居住处墙体发霉,所以考虑是否有曲霉菌的吸入。
视频加载中...
/视频:肺部CT/
但是肺泡灌洗液二代测序结果为阴道加德纳菌,我第一个反应就是「这个结果没有意义」。

我们再看一下背景,这是肺泡灌洗液测到的细菌,细菌很多。我看到结果后,首先感到非常自责,觉得自己操作的气管镜检查可能有污染,居然测出这么多细菌!但我回想,自己操作气管镜检测的时候比较认真,难道是这个病人的个人卫生太差了?


再回来看阴道加德纳菌,这个细菌是阴道炎最常见的致病菌。于是我们与微生物室、临床、病人沟通,主管医生把病人「关到小黑屋」反复详细询问病史半个小时后得出结论。
看完下面这项临床观察研究,再告诉大家这个病例的结果
这是一项前瞻性、多中心的观察性研究,2018年8月至12月期间浙江大学医学院附属邵逸夫医院、浙江大学医学院附属第一医院、浙江省人民医院、浙江省中医院、杭州市第一人民医院、浙江大学医学院附属儿童医院共6家三甲医院,临床诊断肺部感染患者肺泡灌洗液分别进行传统病原微生物检测和二代测序宏基因组病原微生物检测,比较NGS在病原体检测上是否具有优效性。

混合感染的检出优势
对于混合感染的诊断,与传统方法相比,NGS具有更高的敏感性。

对以链球菌为代表的苛养病原体的鉴定具有优势

PJP检出敏感性高

以巨细胞病毒为代表的DNA病毒检出敏感性高
定量PCR方法检测肺泡灌洗液中的巨细胞病毒DNA,阳性3例;mNGS则检测到7例阳性的巨细胞病毒DNA,包括了所有3例传统PCR阳性的病例。
结核劣势和非结核分枝杆菌优势

曲菌:mNGS要结合涂片、培养、GM试验等多个证据共同诊断

mNGS应用及注意事项
mNGS对于苛养病原体的鉴定具有巨大优势;对于细菌和病毒来说,mNGS的敏感性高,能快速做出病原诊断;免疫缺陷患者做广谱病原筛查有意义;在结合临床后阴性结果具有一定的病原菌感染的排除价值,但是在很多情况下的阴性结果,比如核酸抽提困难,真菌、结核都存在假阴性可能;无论是采集方法、测序期间标本的处理或者后续在算法上的问题,都可以导致假阳性。因为我们以前都是靠培养的方法诊断感染性疾病,一旦使用非培养方法可能会在病原谱认识上造成冲击;mNGS可能颠覆我们在感染性疾病上的认知,但一旦和临床认知不同时,一定要去验证,比如上述病例2中的猫立克次体。
总结
感染性疾病病原诊断要以患者为中心,临床起主导作用,病理学、微生物学、影像学、mNGS都是帮助我们做病原学诊断,最终还是要回到患者本身。所以临床与各个部门以及患者的沟通是最重要的。
对于mNGS来说,可以说为病原学诊断又打开了一扇新的窗户,我们一定要大胆的实践,要了解它的优势和缺点,但是拿到结果时要小心求证,掌握新前沿。
最后公布病例3中的阴道加德纳菌,这个病人为女性同性恋。
致谢:

